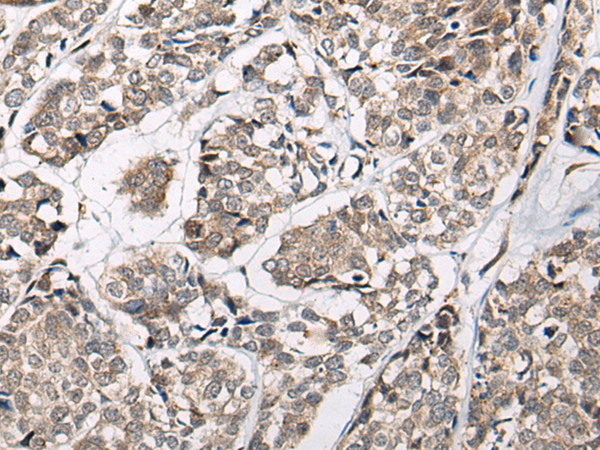

中文名稱:兔抗CACNB3多克隆抗體
英文名稱: Anti-CACNB3 rabbit polyclonal antibody
別 名: CAB3; CACNLB3
相關(guān)類別: 一抗
儲 存: 冷凍(-20℃)
宿 主: Rabbit
抗 原: CACNB3
反應(yīng)種屬: Human, Mouse, Rat
標(biāo) 記 物: Unconjugate
克隆類型: rabbit polyclonal
技術(shù)規(guī)格
|
Background: |
This gene encodes a regulatory beta subunit of the voltage-dependent calcium channel. Beta subunits are composed of five domains, which contribute to the regulation of surface expression and gating of calcium channels and may also play a role in the regulation of transcription factors and calcium transport. |
|
Applications: |
ELISA, IHC |
|
Name of antibody: |
CACNB3 |
|
Immunogen: |
Synthetic peptide of human CACNB3 |
|
Full name: |
calcium voltage-gated channel auxiliary subunit beta 3 |
|
Synonyms: |
CAB3; CACNLB3 |
|
SwissProt: |
P54284 |
|
ELISA Recommended dilution: |
5000-10000 |
|
IHC positive control: |
Human esophagus cancer |
|
IHC Recommend dilution: |
40-200 |
購物車
幫助
021-54845833/15800441009
